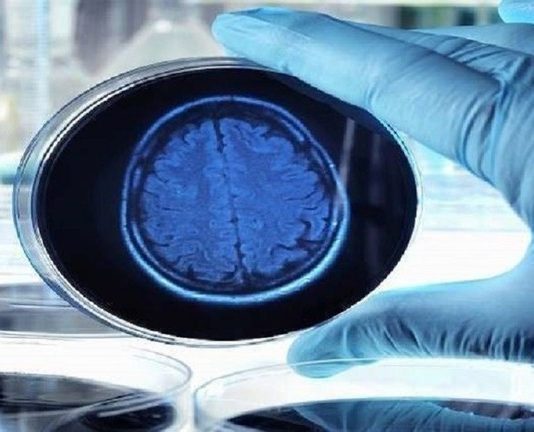

في الوقت الذي يستمتع فيه العالم بمتابعة مباريات "كوبا أميركا"، نجح صبي برازيلي في السادسة من عمره في استقطاب اهتمام وسائل الإعلام، وذلك بسبب...
ذكرت تقارير صحفية في ولاية نيويورك الأميركية، أن إحدى المدارس الثانوية المرموقة، هزتها فضيحة "غش"، في الآونة الأخيرة، إثر ضبط طالب ينقل الأجوبة من...
أعرب رجل بريطاني عن حبه الكبير تجاه ابنه، بطريقة أثارت إعجابا وتعاطفا واسعين على مواقع التواصل، حينما اجتاز الطفل محنة صحية وأجرى عملية جراحية...
عاشت مسافرة كندية لحظات من الرعب، على متن طائرة، بعدما انصرف الركاب والمضيفون، وظلت عالقة بمفردها في المركبة، لأنها كانت تغط في نوم عميق.
وبحسب...
أصيب عشرة أشخاص على الأقل من جراء إطلاق نار خلال حفل زفاف في مدينة الرصيفة الأردنية..
وقال الناطق الاعلامي باسم مديرية الأمن العام في المدينة،...
يخضع شاب عربي للمحاكمة في مدينة الشارقة الإماراتية بتهمة إرسال رسائل "واتس أب" لفتاة فيها عبارات غير لائقة، من ضمنها جملة "خلينا نطلع نغير...
عاشت مسافرة كندية لحظات من الرعب، على متن طائرة، بعدما انصرف الركاب والمضيفون، وظلت عالقة بمفردها في المركبة، لأنها كانت تغط في نوم عميق.
وبحسب...
انطلقت في باريس فعاليات بطولة فرنسا المحلية "أغرب لحية وشاربين"، التي تقام كل عام في شهر يونيو.
وتجذب المسابقة التي تقام كل عامين، في بلاد...
كشفت دراسة حديثة أجراها مستشفى باريس، Versailles، أن الأفراد الذين يعملون ساعات طويلة هم أكثر عرضة للإصابة بسكتة دماغية.
ووجدت الدراسة أن الموظفين العاملين تبعا...
أشار بحث جديد إلى أن مرض ألزهايمر قد يكون ناجما عن الشعيرات الدموية في المخ التي يتم ضغطها.
وغالبا ما يكون ضعف تدفق الدم عبر...